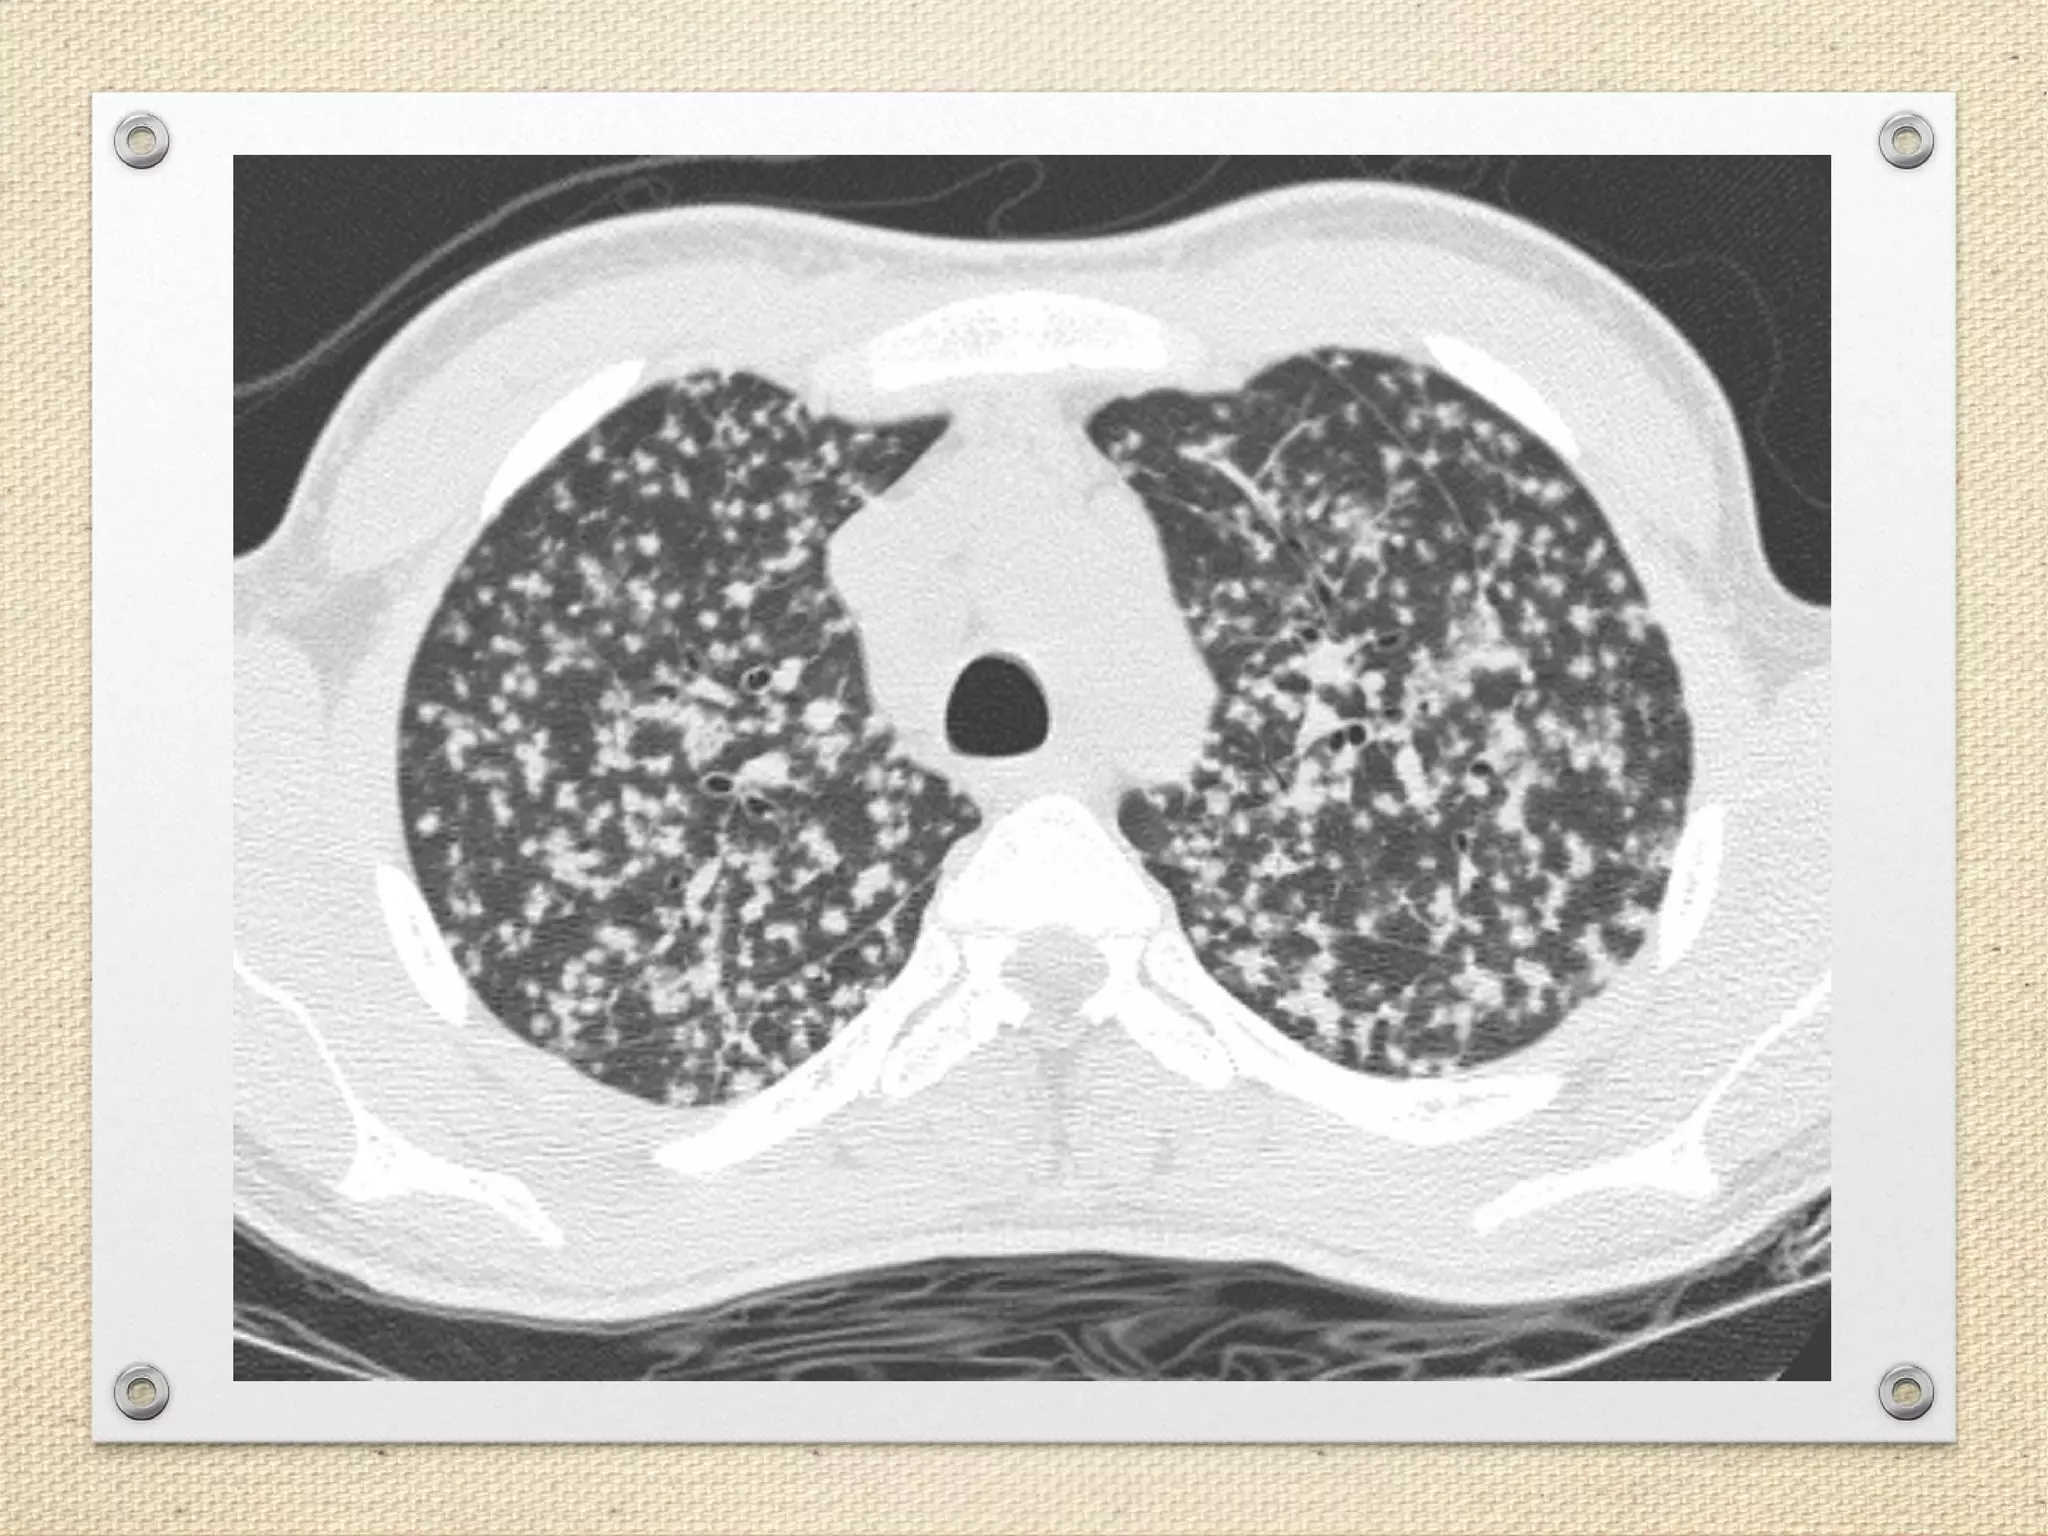
Understanding the tuberculosis granuloma: the matrix revolutions: Trends in  Molecular Medicine, image size:2048x1536

Hajjency
Gallery · April 20, 2025
Miliary Tuberculosis
Miliary Tuberculosis Miliary tuberculosis and disseminated intravascular coagulation A case report


Miliary Tuberculosis | New England Journal of Medicine
image size: 1422x642

Miliary tuberculosis in a patient with end-stage liver disease | Cleveland Clinic Journal of Medicine
image size: 1800x1053

Miliary TB: Differential Diagnosis, Vs. Pulmonary Tuberculosis, More
image size: 1296x728

Miliary Tuberculosis with Acute Respiratory Distress Syndrome: A Deadly Combination | Cureus
image size: 986x887

Facts About Tuberculosis: Symptoms, Vaccine, and Treatment. – Urgent Medical Center
image size: 5001x4001

Miliary Tuberculosis | New England Journal of Medicine
image size: 2640x2667

Central Nervous System Complications in Miliary Pulmonary Tuberculosis: A Systematic Review Of Published Case Reports And Case Series | medRxiv
image size: 1280x1199

A Case Report on Miliary Tuberculosis in Acute Immune Reconstitution Inflammatory Syndrome - JETem
image size: 2012x2012

Pulmonary adenocarcinoma mimicking miliary tuberculosis in a 20‐year‐old man: A clinical case report - Seifi - 2023 - Clinical Case Reports - Wiley Online Library
image size: 2128x1061
70163-8/asset/26e9e802-c402-44cf-9283-6bdbaf45095b/main.assets/gr4_lrg.jpg)
Miliary tuberculosis: new insights into an old disease - The Lancet Infectious Diseases
image size: 1261x1412

Imaging of Pulmonary Miliary Tuberculosis With Multiple Intracranial Tuberculomas | Cureus
image size: 986x874

Miliary Histoplasmosis Mimicking Miliary Tuberculosis in a Patient Treated with Tumor Necrosis Factor-α Inhibitor Therapy | The Journal of Rheumatology
image size: 1800x823

Miliary tuberculosis - WikiProjectMed
image size: 1280x952

Miliary tuberculosis in a patient with end-stage liver disease | Cleveland Clinic Journal of Medicine
image size: 1800x1406

An Unusual Case of Multidrug Resistant Miliary Tuberculosis
image size: 1000x838

Presumed Miliary TB : r/Radiology
image size: 2887x3320

TB Miliary Disease | The Common Vein
image size: 1198x848

Types Tuberculosis Miliary Disseminated Pulmonary Tuberculosis Stock Vector (Royalty Free) 390068365 | Shutterstock
image size: 1500x1042

Miliary tuberculosis hi-res stock photography and images - Alamy
image size: 1300x956

Frontiers | Should miliary tuberculosis be considered as a possible cause of infertility in the new era: a case report and literature review
image size: 3150x1250

Case 97: How to Identify and Diagnose Miliary TB as a Cause of ARDS
image size: 2000x1125

Miliary Never-Smoking Lung Adenocarcinoma With Large Pleural Effusion Mimicking Tuberculosis | Annals of Internal Medicine: Clinical Cases
image size: 978x1024

File:Miliary TB of the spleen.jpg - Wikimedia Commons
image size: 5173x3381

AlKhatib - 💚💚Military Tuberculosis - B/L diffuse, symmetric, 1- 2 mm, millet shaped shadowing 💚💚D/D of miliary pattern . Infection - miliary TB, histoplasmosis, cryptococcosis, nocardiosis . Inflammatory - HP, sarcoidosis, silicosis .
image size: 1070x963

Figure 4 from Challenges in the diagnosis \u0026 treatment of miliary tuberculosis | Semantic Scholar
image size: 1372x1148

Miliary Lung Lesions Mimicking Tuberculosis: A Case of Metastatic Lung Adenocarcinoma | Cureus
image size: 986x897
70163-8/asset/582d16a8-f559-44c5-9d29-bb8a64c7ee54/main.assets/gr2_lrg.jpg)
Miliary tuberculosis: new insights into an old disease - The Lancet Infectious Diseases
image size: 2960x2986

Miliary Nodularity in a Patient Receiving TNF Inhibitors Is Not Always Miliary Tuberculosis | The Journal of Rheumatology
image size: 1332x958

File:Miliary Tuberculosis.jpg - wikidoc
image size: 1476x1602

Miliary Tuberculosis in an Immunocompetent Male with Central Nervous System Involvement - The American Journal of Medicine
image size: 1500x2016

EPOS\u0026trade;
image size: 1024x768

Not all that is miliary is tuberculosis: metastatic medullary thyroid carcinoma mimicking miliary tuberculosis
image size: 1800x1600

Frontiers | Should miliary tuberculosis be considered as a possible cause of infertility in the new era: a case report and literature review
image size: 1983x1521

Miliary Shadowing 👩\u200d⚕️ Miliary tuberculosis is an uncommon pulmonary manifestation of tuberculosis. It represents haematogenous dissemination of uncontrolled tuberculous infection and carries a relatively poor prognosis. It is seen both in primary
image size: 1080x1080

Miliary tuberculosis in a patient with rheumatoid arthritis treated with tumor necrosis factor-alpha inhibitor - The American Journal of the Medical Sciences
image size: 2500x1807

Miliary tuberculosis occurred after immunosuppressive drug in PNH patient with completely cured tuberculosis; a case report | Annals of Clinical Microbiology and Antimicrobials
image size: 1200x1479

Lung - Miliary tuberculosis | Miliary tuberculosis can occur… | Flickr
image size: 1024x768

Miliary tuberculosis in an immune‐competent Bangladeshi man—A case report - Paul - 2023 - Clinical Case Reports - Wiley Online Library
image size: 1980x1377

Lung: miliary tuberculosis | Wellcome Collection
image size: 801x1176

Pulmonary Tuberculosis: Up-to-Date Imaging and Management | AJR
image size: 1800x1344

Tuberculosis: Causes, Symptoms, Treatment \u0026 Prevention
image size: 800x987

265Lu Miliary TB | The Common Vein
image size: 1043x1061

Miliary tuberculosis | PPTX
image size: 2048x1536

Miliary Calcification of the Lungs after Treated Miliary Tuberculosis | New England Journal of Medicine
image size: 913x1169

Pediatric Tuberculosis Pneumonia | Pediatric Radiology Reference Article | Pediatric Imaging | @pedsimaging
image size: 1100x1100

Atypical Presentation of Miliary Tuberculosis With Hepatic Involvement Early After Renal Transplantation - Clinical Gastroenterology and Hepatology
image size: 2625x2250

Miliary Tuberculosis Vector Illustration On Isolated Stock Vector (Royalty Free) 383199208 | Shutterstock
image size: 1500x1600

Case 97: How to Identify and Diagnose Miliary TB as a Cause of ARDS
image size: 1384x778

Teaching NeuroImage: CT and MRI Radiologic Features and Evolution of Miliary Cerebral Tuberculosis | Neurology
image size: 1338x1016

Miliary Pulmonary Tuberculosis Stock Image - Image of antibiotic, infection: 121413897
image size: 1600x1153

Tuberculosis. Coloured X-ray of a patient's chest showing disseminated, or miliary, tuberculosis (TB) in the lungs. The lungs contain lesions (tubercl Stock Photo - Alamy
image size: 1300x1225
![Miliary Tuberculosis PDF] Miliary tuberculosis: new insights into an old disease. | Semantic Scholar, image size:878x1120](https://figures.semanticscholar.org/2759a8097ed0d867b2b818911b14b3cbe10e622b/7-Figure5-1.png)
PDF] Miliary tuberculosis: new insights into an old disease. | Semantic Scholar
image size: 878x1120

Miliary Tuberculosis, 3D Illustration And Light Micrograph Showing Histopathology Of The Lung Affected By Multiple Tiny Tuberculosis Lesions Stock Photo, Picture and Royalty Free Image. Image 128015492.
image size: 1300x731

Miliary TB - Northumberland Archives
image size: 2000x2560

Sarcoidosis and Tuberculosis: A Case Report and Literature Review
image size: 3543x3269

EPOS\u0026trade;
image size: 1024x768

Pulmonary Tuberculosis: Up-to-Date Imaging and Management | AJR
image size: 1692x1469

14yo male with diffuse miliary tuberculosis and right pulmomary abscess. Poorly treated multidrug resistant. : r/Radiology
image size: 4000x2252

Miliary tuberculosis Symptoms: Fever, chronic cough, weight loss, loss of appetite → classic constitutional symptoms of TB. Chest X-ray: Diffuse, bilateral, fine reticulonodular (“millet seed”) opacities throughout both lungs → hallmark of
image size: 1025x1200

The etiological spectrum of miliary brain lesions: A systematic review of published cases and case series - Ravindra Kumar Garg, Vimal Paliwal, Swastika Suvirya, Hardeep Singh Malhotra, Anoop Verma, 2024
image size: 2800x1720
70163-8/asset/c8214aac-b84b-42fb-8c4e-e3c08cc16a25/main.assets/gr3_lrg.jpg)
Miliary tuberculosis: new insights into an old disease - The Lancet Infectious Diseases
image size: 2760x2849

Miliary Tuberculosis (TB) - Chest Radiology Case Studies - CTisus CT Scanning
image size: 1024x944

Tuberculosis from Head to ToeRadioGraphics
image size: 1256x1280

Pulmonary Adenocarcinoma Mimicking Miliary Tuberculosis in a 20-year-old Male; a Clinical Case Report
image size: 1968x1422

File:Miliary tuberculosis involving kidney (6539942623).jpg - Wikimedia Commons
image size: 801x1038

Miliary tuberculosis and HIV | Wellcome Collection
image size: 1600x935

Diaphragmatic pleura - Miliary tuberculosis | Miliary tuberc… | Flickr
image size: 1355x835

Frontiers | Analysis of Clinical Features and Risk Factors in Pregnant Women With Miliary Pulmonary Tuberculosis After In Vitro Fertilization Embryo Transfer
image size: 574x1694

Multiple Giant Molluscum Contagiosum Mimicking Epidermal Cysts in an HIV-Positive Patient with Miliary Tuberculosis: A Case Report | International Journal of Dermatology and Venereology
image size: 720x1280

MILIARY TUBERCULOSIS , #radiographic_features, ., ., ., ., Follow JAs MedImaging , ., ., ., ., #chest, #xray, #medical , #radiology , #physicians , #healthcare | JAs MedImaging | Facebook
image size: 1280x1280

Erler-Zimmer 3D Printed Right Lung Miliary Tuberculosis | Anatomy Warehouse
image size: 986x891

Systemic Manifestation of Miliary Tuberculosis in Patient With Advanced Diabetic Retinopathy Presenting With Electrolyte Imbalance, Seizures, and Adrenal Insufficiency | Cureus
image size: 960x974

aruaclinic @BrownJHM @ChefKarim02 @DrCindyCooper @drkeithsiau @rkalyes1 @imedverse @NiravValand30 Miliary tuberculosis is a potentially fatal form of disseminated disease due to the hematogenous spread of tubercle bacilli to the lungs and other organs ...
image size: 763x1412

265Lu Miliary TB | The Common Vein
image size: 1300x823

Types Of Tuberculosis. Miliary And Disseminated Pulmonary Tuberculosis. Infographics. Illustration On Isolated Background. Royalty Free SVG, Cliparts, Vectors, and Stock Illustration. Image 53106491.
image size: 2591x2951

Radioloksabha - Articles
image size: 2507x2396
Understanding the tuberculosis granuloma: the matrix revolutions: Trends in Molecular Medicine
image size: 2048x1536

Miliary Tuberculosis (dr. mahesh) | PPT
image size: 1100x1100

Pediatric Tuberculosis Pneumonia | Pediatric Radiology Reference Article | Pediatric Imaging | @pedsimaging
image size: 1600x990

Miliary Tuberculosis, Illustration and Light Micrograph Stock Illustration - Illustration of lung, eosin: 155023688
image size: 1312x736

Which Type of TB Is Dangerous: A Comprehensive Guide
image size: 667x1394

Difficulties in distinguishing silicosis and pulmonary tuberculosis in silica‐exposed gold miners: A report of four cases - Maboso - 2023 - American Journal of Industrial Medicine - Wiley Online Library
image size: 1024x768

EPOS\u0026trade;
image size: 1155x1024

Infection Landscapes: Tuberculosis
image size: 1920x1191

Qure.ai Announces World's First AI-Powered Paediatric TB Screening Tool to Extend Proactive Reach from Birth to 15 Years | Reuters
image size: 1300x1202

Miliary tuberculosis. X-ray of the chest of a patient with miliary tuberculosis (TB). Affected areas of the lungs (black) are shown by grainy white pa Stock Photo - Alamy
image size: 2800x1832

The etiological spectrum of miliary brain lesions: A systematic review of published cases and case series - Ravindra Kumar Garg, Vimal Paliwal, Swastika Suvirya, Hardeep Singh Malhotra, Anoop Verma, 2024
image size: 1000x1080

Military tuberculosis – Royalty-Free Vector | VectorStock
image size: 1600x1200

Motic Europe | Blog: Miliary TBC
image size: 4000x2252

14yo male with diffuse miliary tuberculosis and right pulmomary abscess. Poorly treated multidrug resistant. : r/Radiology
image size: 1080x1800

Tuberculosis: A Radiologic ReviewRadioGraphics
image size: 1024x786

Miliary Tuberculosis (TB) with Tree in Bud Appearance - Chest Radiology Case Studies - CTisus CT Scanning
image size: 1000x1000

Miliary Tuberculosis In Childs Lung Framed Print by Wellcome Images - Science Source Prints
image size: 2525x1728

Challenges in the diagnosis \u0026 treatment of miliary tuberculosis
image size: 1600x1167

File:Lung - Miliary tuberculosis (6572340291).jpg - Wikimedia Commons
image size: 2160x1950

Miliary tuberculosis and disseminated intravascular coagulation: A case report
image size: 1500x945
Discover more galleries
- October 2, 2025 New 16x80 Clayton Mobile Homes /2025-10-02/new-16x80-clayton-mobile-homes
- February 18, 2025 Hayes Martial Arts /2025-02-18/hayes-martial-arts
- July 3, 2025 Vogue Cover 2013 /2025-07-03/vogue-cover-2013
- October 19, 2025 Pirámide Alimenticia Fondo En Blanco /2025-10-19/piramide-alimenticia-fondo-en-blanco